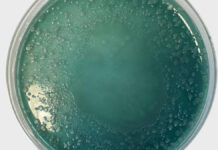
Kontrola sanepidu w salonie beauty

Fulereny biologiczne. Nowa era w nanokosmetologii. Golden Mist zmienia przyszłość pielęgnacji profesjonalnej
Misją IMU Medical S.A. jest dostarczanie produktów, które działają szybko, skutecznie i głęboko, jednocześnie pozostając bezpieczne oraz intuicyjne w codziennym stosowaniu. Właśnie z tej...
Hipoksja a starzenie skóry
Hipoksja to stan niedotlenienia tkanek, który może być wywoływany przez różne czynniki. Organizmy rozwinęły mechanizmy adaptacji w hipoksji, a podstawowy mechanizm wiąże się z...
Zmiany skórne w okresie menopauzy – fizjologia, objawy i celowana pielęgnacja
Menopauza to czas intensywnych zmian fizjologicznych, które wpływają nie tylko na ogólne samopoczucie kobiety, ale również na kondycję jej skóry. Wraz z wydłużającym się...
Alergeny w kosmetykach a trądzik różowaty
Wielu konsumentów zakłada, że składniki kosmetyczne oznaczone jako bezpieczne lub naturalne są odpowiednie dla każdego rodzaju skóry. Okazuje się, że niektóre substancje, choć formalnie...
Medycyna regeneracyjno-naprawcza wieku dojrzałego
Długofalowe prowadzenie terapii przeciwstarzeniowych u osób dojrzałych, przy obecnym stanie wiedzy i postępie technologicznym,stawia specjalistom poważne wyzwania. Prawidłowa diagnoza oraz dobór spersonalizowanej terapii stają...
Terapie laserowe w zabiegach estetycznych – wielokierunkowe działanie i synergia
Laserowe terapie łączone umożliwiają interdyscyplinarne podejście do wielu problemów skórnych. Medycyna estetyczna i kosmetologia nie sprowadzają się tylko do aspektów estetycznych. Obecnie wprowadzany nurt...
Zabiegi aparaturowe, które warto wykonywać zimą
Niższe temperatury i ograniczona ekspozycja na promieniowanie UV tworzą warunki szczególnie sprzyjające wykonywaniu bardziej intensywnych zabiegów aparaturowych. Chłód powoduje fizjologiczne zwężenie naczyń krwionośnych, dzięki...
Kontrola sanepidu w salonie beauty
Kontrola sanepidu to jeden z tych momentów, który u właścicieli salonów beauty potrafi wywołać przyspieszone bicie serca. Niezależnie od tego, czy mowa o gabinecie...